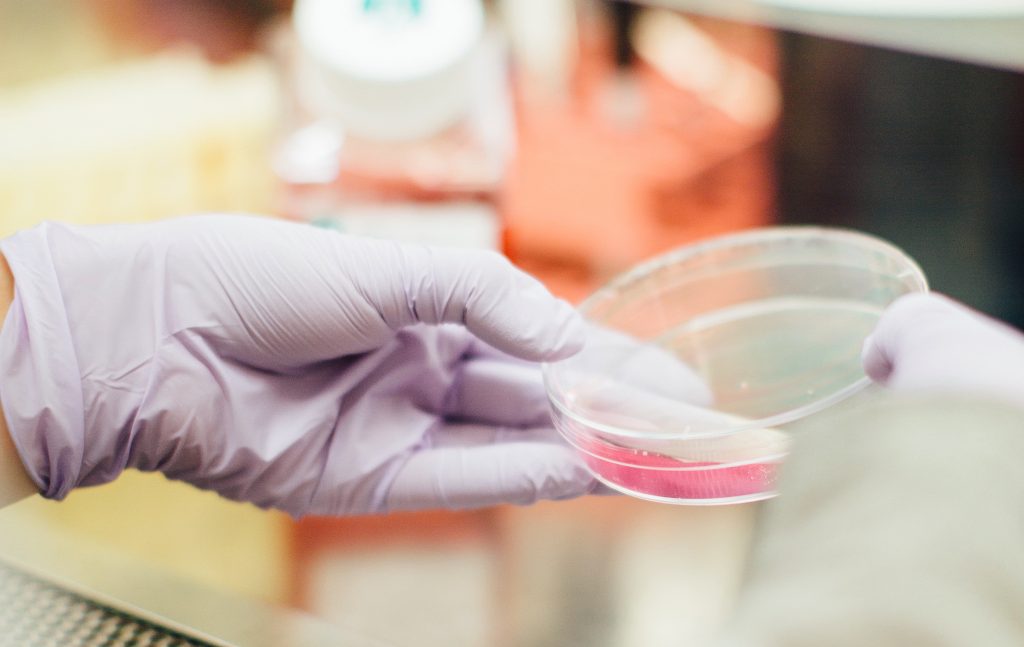

Successful pitches are the single biggest way to completely up your publishing track record.
But the sad thing is, it’s also the biggest area in which most aspiring, struggling, and even working writers with flourishing businesses flounder.
It seems to be some sort of magic, this pitching thing. Like you can try your hardest and make the most delightful, engaging, polished pitch, and then, once you’ve sent it out to an editor’s inbox, it’s on an Odyssey-like journey.
Does the pitch even make it?
Does some monster delete it before it even gets read?
Does a cackling Greek chorus laugh it off stage before it gets a moment to monologue?
Will you spend decades knitting a funeral shroud for it because you think it’s died out there somewhere but you’re never quite sure?
It’s Not Magic, Rocket Science, or Skill
Successful pitches is 100% formula, and I’ve talked in detail about what that formula for the structure of the pitch is. But people often skip the most important premise. It comes long before the pitch is sketched out, the details researched, and the words written.
Successful pitches are purely a combination of what works all the time with a firm grasp on what is unique about this situation.
This is really all you need to know about pitching to knock it out of the park. But let’s break it down.
All successful pitches have some elements that are the same:
- detail-driven, succinct writing
- clarity
- a strong lead
- an outline of what the article will cover/the arc of the story
- convincing proof that you should be the one to write the piece
Discover More Inspiration:
- What You Do 60% of the Time is What You Do
- Business Planning Doesn’t Work for Creatives (or Anyone Really). Here’s What to Do Instead
- How to Be Your Own Unerring Sounding Board for Any Freelance Problem
But several important elements of the pitch need to change every time:
- the recipient of the pitch
- the tone of the pitch (i.e., the tone of the magazine you are pitching)
- the level of familiarity of the pitch
- the section of the magazine the pitch is destined for
- the depth of detail in the pitch (which depends on the length of the piece you are pitching and how well you know the editor)
- the idea you are pitching
When you look at these aspects of your pitch concretely and logically, like sliders that are adjusted in one direction or another just as you do when you are editing a photo, the process of perfecting each pitch to its full potential becomes much more palatable.
It becomes a process—a list of boxes you can check and clear decisions you can make. As opposed to a blank slate staring you down and creating a game of chicken with the equally blank stare of your bank balance.
Look at your next pitch as a system, a process, a steampunk machine into which you input an idea and a magazine and a pitch pops out rather than an exercise inputting yourself on the line.
I’ve seen this perspective shift make all the difference for my coaching clients, and I’m excited to hear what it can do for you for successful pitches.
Want to Expand Your Expertise on This Topic?
Check out our info-packed video courses to go in-depth and quickly skill up. People have called them “a wealth of knowledge” and “invaluable tools,” and told us “you do an amazing job of helping people,” and “I am learning more from you than any other person.”

